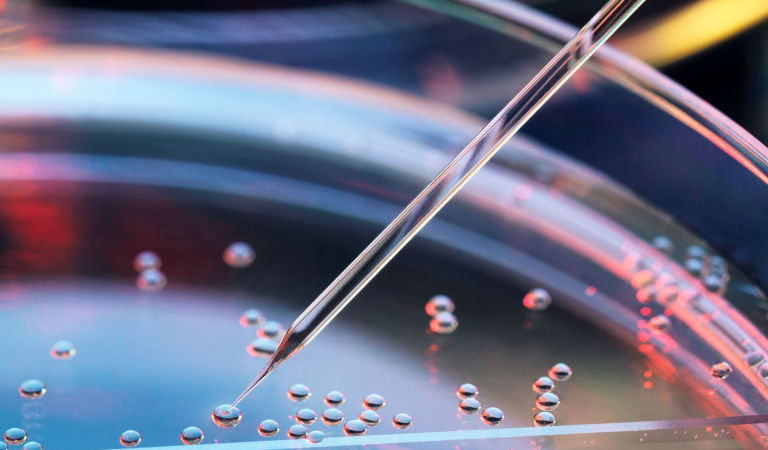
bio-medical-fund-close

BOSTON, 13 APRIL 2023 — Wellington Management (“Wellington” or the “Firm”), one of the world’s largest independent investment management firms, today announced the close of Wellington Biomedical Innovation II (“Biomed” or “Biomed II”), with approximately US$476 million in commitments. Led by Wellington’s dedicated private market biotech investing team, the Fund invests in private biotech companies that are developing the next generation of treatments that seek to improve the standard of care in medicine.
In addition to the lifesaving potential of these innovations, global demand for high-impact drugs and therapies is spurred by demographic trends such as the rapidly aging population of developed markets, economic growth, and demand among emerging markets for modern biopharma and medical devices. The Biomed investment team is led by experienced biotech investors I-Hung Shih, PhD and Nilesh Kumar, PhD and includes Irina Margine, PhD and Ross Castillo, MD. The team leverages the Wellington platform, collaborating closely with Wellington’s global health care team, which manages more than US$67 billion in assets. In 2019, Biomed I closed at approximately US$394 million in commitments.
I-Hung Shih, Co-Head, Biotech Private Investments at Wellington Management, said, “We think there is an accelerated pace of innovation underway within biotech and life sciences companies across developed and emerging markets. The rise of new and changing global demographics coupled with breakthrough drugs, therapies and preventative care are driving secular long-term growth. We see an exciting set of investment opportunities with potential to become industry leaders capable of transforming the standard of medicine as we know it.”
Nilesh Kumar, Co-Head, Biotech Private Investments at Wellington Management, added, “As part of one of the world’s largest healthcare investors, we have exposure to some of the most innovative companies in life sciences. We share a wide perspective on the cycle of innovation and drug development in biotech and biopharma when evaluating our opportunity set. Further, our private and public platforms aim to foster long-term relationships with our portfolio companies as we seek to generate value for both our companies and investors.”
The Fund has made four investments to date. Its investor base includes, among others, insurance companies, foundations, family offices, and a sovereign wealth fund.
About Wellington Management
Wellington Management is one of the world’s largest independent investment management firms, serving as a trusted adviser to over 2,400 clients in more than 63 countries. The firm manages more than US$1.1 trillion for pensions, endowments and foundations, insurers, family offices, fund sponsors, global wealth managers, and other clients. Wellington aspires to provide excellent service to clients through a unique combination of independence enabled by its distinctive private partnership model, diverse perspectives through its unified, multi-asset investment platform, and relentless curiosity and intellectual rigor fostered by its enduring collaborative culture.
About Wellington Management Private Investing
The Wellington Private Investing platform has a dedicated team that invests across multiple sectors and stages of the private markets and leverages the firm’s more than 1000 investment professionals located in offices around the world. From early-stage venture to late-stage growth, the team actively invests across the business lifecycle in the next generation of industry defining entrepreneurs and changemakers. The team has raised over US$7.5 billion in global assets to invest across geographies (Asia, Europe, and the Americas) and sectors (consumer, technology, health care, financial services, biotechnology, and climate technology). Wellington’s dedicated Private Investing team takes a long-term view and leverages both its deep private market expertise along with Wellington’s broader public market expertise, extensive network, and robust research across its global footprint to benefit both investors and entrepreneurs. For more information about Wellington Private Investing, please visit wellington.com/privateinvestments.
Press inquiries
Wellington Management – Robyn Tice, rtice@wellington.com
Prosek Partners – pro-wellington@prosek.com